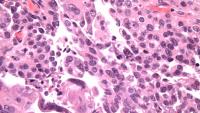
Ovarian cancer - high grade serous carcinoma of tubo-ovarian origin

Jason D. Wright, MD
On the web

Overview
Dr. Wright completed residency and a fellowship in Gynecologic Oncology at Washington University in St. Louis. He is board certified in Obstetrics and Gynecology and Gynecologic Oncology. Dr. Wright sees women with all gynecologic cancers and has extensive training in minimally invasive surgery, extended pelvic resections, and pelvic reconstructive surgery. Dr. Wright also cares for a large number of women with hereditary cancer syndromes. In addition, Dr. Wright sees women with who require complex gynecologic procedures.
Dr. Wright is an internationally recognized expert in the treatment of gynecologic cancers and gynecologic surgery. He has authored over 600 articles, chapters, and textbooks. A major focus of Dr. Wright's work is the delivery of quality care to patients with cancer and the improvement of outcomes for patients with gynecologic cancer. Dr. Wright's primary clinical research focuses on the evaluation of novel therapeutics and the early detection and prevention of gynecologic cancer. Dr. Wright is the principal investigator on a number of clinical trials. He currently serves as Editor-in-Chief of Obstetrics & Gynecology, a leading academic journal in the field.
Areas of Expertise / Conditions Treated
- Cervical Cancer
- Cervical Dysplasia
- Da Vinci Robotic Surgery
- Endometrial Cancer
- Gestational Trophoblastic Disease
- Gynecologic Cancer
- Human Papillomavirus (HPV)
- Laparoscopic Gynecologic Surgery
- Ovarian Cancer
- Ovarian Cancer Genetic Susceptibility
- Placenta Accreta Spectrum (PAS)
- Robotic Gynecologic Surgery
- Uterine Cancer
- Vaginal Cancer
- Vulvar Cancer
Academic Appointments
- Sol Goldman Associate Professor of Gynecologic Oncology (in Obstetrics and Gynecology)
Administrative Titles
- Chief, Division of Gynecologic Oncology
- Vice Chair of Academic Affairs, Department of Obstetrics and Gynecology
Hospital Affiliations
- NewYork-Presbyterian / Columbia University Irving Medical Center
Gender
- Male
Schedule an Appointment
Virtual Visits/Telehealth
Virtual Visits allow you to connect with your provider from the comfort, convenience, and safety of your own home.
Connect Patient Portal
For existing patients, login to make an appointment, view documentation or contact your care provider.
Location(s)
Insurance Accepted
Aetna
- Aetna Signature Administrators
- EPO
- HMO
- Medicare Managed Care
- NY Signature
- POS
- PPO
- Student Health
Affinity Health Plan
- Essential Plan
- Medicaid Managed Care
Amida Care
- Special Needs
Cigna
- EPO
- Great West (National)
- HMO
- Medicare Managed Care
- POS
- PPO
Emblem/GHI
- Medicare Managed Care
- PPO
Emblem/HIP
- ConnectiCare
- EPO
- Essential Plan
- HMO
- Medicaid Managed Care
- Medicare Managed Care
- POS
- PPO
- Select Care (Exchange)
- Vytra
Empire Blue Cross/Blue Shield
- EPO
- HMO
- Medicare Managed Care
- PPO
Empire Blue Cross Blue Shield HealthPlus
- Child/Family Health Plus
- Essential Plan
- Medicaid Managed Care
Fidelis Care
- Child/Family Health Plus
- Essential Plan
- Medicaid Managed Care
- Medicare Managed Care
Healthfirst
- Child/Family Health Plus
- Leaf (Exchange)
- Medicaid Managed Care
- Medicare Managed Care
Local 1199
- Local 1199
MagnaCare (National)
- MagnaCare
Medicare
- Railroad
- Traditional Medicare
Multiplan
- Multiplan
MVP Health Care
- Child/Family Health Plus
- Essential Plan
- HMO
- Medicaid Managed Care
RiverSpring
- Special Needs
UnitedHealthcare
- Columbia University Employee Plan
- Compass (Exchange)
- Empire Plan
- HMO
- Medicaid (Community Plan)
- Medicare Managed Care
- Oxford Freedom
- Oxford HMO
- Oxford Liberty
- POS
- PPO
VNSNY CHOICE
- Medicare Managed Care
- SelectHealth
- Special Needs
WellCare
- Medicaid Managed Care
- Medicare Managed Care
World Trade Center Health Plan
- World Trade Center Health Plan
Credentials & Experience
Education & Training
- Internship: Barnes Jewish Hospital-Washington University School of Medicine
- Residency: Barnes Jewish Hospital-Washington University School of Medicine
- Residency: 2003 Obstetrics and Gynecology, Barnes-Jewish Hospital
- Fellowship: Barnes Jewish Hospital-Washington University School of Medicine
Board Certifications
- Obstetrics and Gynecology
- Gynecologic Oncology
Research
For a complete list of publications, please visit PubMed.gov